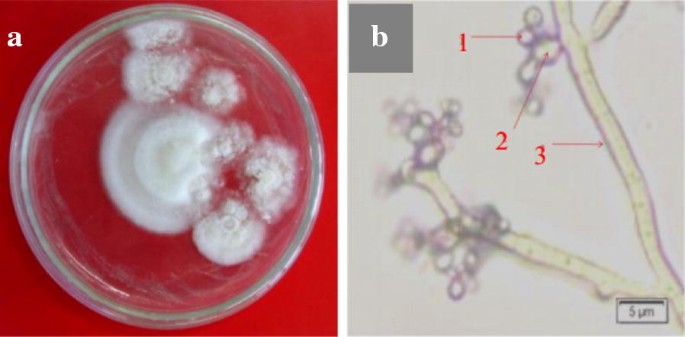
figure 2

- Research
- Open access
- Published:
Endophytic fungi Beauveria bassiana Balsamo accelerates growth of common bean (Phaeseolus vulgaris L.)
Chemical and Biological Technologies in Agriculture volume 6, Article number: 11 (2019)
Abstract
Background
Common bean (Phaseolus vulgaris L.) is a source of antioxidant-containing vegetable protein that is beneficial to human health. The intense cultivation of common bean may result in environmental degradation. Thus, environmentally friendly cultivation methods that use an endophyte to improve productivity are needed. An entomopathogenic fungus, Beauveria bassiana, can serve as an endophyte that stimulates the growth of Gossypium. Therefore, we isolated and identified B. bassiana and also examined its function as a beneficial endophyte that promotes the growth of common bean.
Results
An entomopathogenic fungus, B. bassiana, was collected and identified based on macroscopic and microscopic characteristics that were observed during morphological examination. B. bassiana was propagated and inoculated into common bean via seed soaking, soil wetting, and leaf spraying. The soil-wetting and leaf-spraying methods used to inoculate B. bassiana effectively enhanced the growth of common bean, which was observed at day 10 post-inoculation. However, no significant growth enhancement of common bean was observed when the seed-soaking inoculation method was used.
Conclusions
These results suggest a positive correlation between the B. bassiana inoculation method and growth enhancement of common bean. This study showed the endophytic potency of the fungus that may be used in the development of environmentally friendly cultivation methods of common bean.

Introduction
Common bean (Phaseolus vulgaris L.) is a source of antioxidant-containing vegetable protein and is widely consumed in various countries. Beninger and Hosfield [5] showed that pure flavonoid compounds that are present in the seed coats of common bean, such as anthocyanins, quercetin glycosides, and proanthocyanidins (condensed tannins), have significant antioxidant activity that is related to butylated hydroxytoluene (BHT), a commercial antioxidant used in foods. Consumption of common bean may increase levels of antioxidants, which is beneficial to human health. However, intense cultivation of common bean may result in environmental degradation, as well as planting of beans (Phaseolus vulgaris L.) in Northern Nicaragua [21]. Thus, environmentally friendly cultivation methods that improve productivity, such as using Beauveria bassiana as an endophyte, are needed.
Biological agents can be a positive trigger of plant growth. Entomopathogenic B. bassiana is thought to have a broad host range and has the potential of being used as a biological control agent by serving as an endophyte capable of protecting plants. For example, colonization of the sweet pepper Capsicum annum by B. bassiana could suppresses aphids in controlled greenhouse conditions as part of an Integrated Pest Management (IPM) approach [8]. Moreover, B. bassiana may also be isolated from common bean by PDA media [16].
According to Lopez and Sword [12], the endophytic ability of B. bassiana can stimulate the growth of Gossypium hirsutum by suppressing the population of Helicoverpa zea and by helping to transfer nutrients from the soil into the roots of the plant. Endophytic fungi can be introduced onto plants by seed-soaking, leaf-spraying, and soil-wetting initiation methods using suspensions of B. bassiana. The seed-soaking method has been demonstrated to effectively promote endophytic development of B. bassiana on bean plants [4]. Leaf-spraying and soil-wetting methods successfully introduced endophytic B. bassiana onto peanut plants [16]. In this study, B. bassiana inoculation methods and its function as a growth-promoting endophytic fungus in the common bean (Phaseolus vulgaris L.) were evaluated.
Materials and methods
Plants and endophytic fungi
Common bean varieties of balitsa 2 were obtained from the Unit of Seed Sources of Vegetable Research Institute, Bandung. The plant optimally grows 400–500 m above sea level, with a productivity yield of 20–23.8 tons per hectare. Isolates of B. bassiana were obtained from our collection in the Plant Protection Laboratory, Universitas Brawijaya, Malang. B. bassiana was grown in PDA media [16] and was identified according to genera of imperfect fungi [3].
Inoculation of B. bassiana onto common bean
This study used a completely randomized design that consisted of six groups of treatments and four replications. Twenty-four plants were divided into six groups that were inoculated with B. bassiana by three methods: seed-soaking, leaf-spraying, and soil wetting; the remaining three groups were used as controls for each method. The number of colonies and plant growth parameters were determined at 10 days and 20 days post-inoculation to monitor the effects of the treatments. B. bassiana suspensions at a concentration of 1 × 108 conidia per ml with greater than 80% viability were used as inoculants. The seed-soaking method consisted of soaking common bean seeds with 0.5% sodium hypochlorite (NaOCl) with constant shaking, soaking the seeds in 70% ethanol, then rinsing the seeds with distilled water three times (2 min per rinse) [16]. The seeds were then soaked for 30 min with B. bassiana (1 × 108 conidia per ml) or with 10 ml of sterile water as a control treatment. Leaf-spraying and soil-wetting were performed 14 days after planting. Leaf-spraying was performed by manually spraying leaves with 10 ml of a B. bassiana suspension and then covering the plants with a plastic bag for 24 h to maintain humidity. Soil-wetting was performed by irrigating the soil with 10 ml of a B. bassiana suspension and then covering the top of the soil with aluminium foil.
Measurement of plant growth
Observations of plant growth were performed at 10 and 20 days following inoculation. Measurements included plant height, root length, and number of leaves.
Bassiana colonization
Beauveria bassiana colonization tests were performed on leaves, stems, and roots. Each leaf, two pieces of root, and two pieces of stem were taken from the common bean plant and were then planted on PDA medium. Macroscopic and microscopic examinations were conducted to confirm that colonized B. bassiana were endophytes.
Statistic analysis
The following formula was used to calculate B. bassiana colonization:
The results were then analyzed by analysis of variance (ANOVA) at 95% confidence level.
Results
Identification of B. bassiana
Beauveria bassiana grows on the edges of roots, stems, and leaves on PDA medium and is white and round in appearance with a smooth edge texture (Fig. 1). During growth, B. bassiana colonies spread regularly. Macroscopic and microscopic identification was based on a previous publication [3]. Macroscopic characteristics of endophytic B. bassiana include white color, textured smooth edges, irregular scattering, and a diffuse distribution. The surface texture of a colony is rather coarse and the colony grows rather tightly (Fig. 2a). Microscopically, endophytic B. bassiana are characterized by hyaline-colored sectional hyphae with a width of 1.10 μm, round-to-oval hyaline-colored conidia with a diameter of 1.47 μm, and a collection of conidia clustered in Konidiofor (Fig. 2b).
Bassiana colonization
Three inoculation methods (seed-soaking, leaf-spraying, soil-wetting) were tested using three different B. bassiana inocula amounts and two different post-inoculation times (10 and 20 days). At 10 days post-inoculation with the seed-soaking method, root colonization was 37.50 ± 12.50 colonies, stem colonization was 25.64 ± 12.50, and leaf colonization was 33.34 ± 16.67 (all controls were 0.00 ± 0.00). At 10 days post-inoculation with the leaf-spraying method, root colonization was 62.50 ± 23.94, stem colonization was 62.50 ± 12.50, and leaf colonization was 66.92 ± 18.00 (all controls were 0.00 ± 0.00). At 10 days post-inoculation with the soil-wetting method, root colonization was 87.50 ± 12.50, stem colonization was 62.50 ± 23.94, and leaf colonization was 46.09 ± 10.65 (all controls were 0.00 ± 0.00).
At 20 days post-inoculation with the seed-soaking method, root colonization was 16.67 ± 12.50, stem colonization was 12.50 ± 12.50, and leaf colonization was 8.34 ± 9.62 (all controls were 0.00 ± 0.00). At 20 days post-inoculation with the leaf-spraying method, root colonization was 25.00 ± 12.50, stem colonization was 25.00 ± 14.43, and leaf colonization was 33.59 ± 30.80 (all controls were 0.00 ± 0.00). At 20 days post-inoculation with the soil-wetting method, root colonization was 37.50 ± 12.50, stem colonization was 25.00 ± 14.43, and leaf colonization was 25.00 ± 16.67 (all controls were 0.00 ± 0.00).
The results of these experiments showed that B. bassiana was present in common bean tissue and that B. bassiana colonies grew in roots, stems, and leaves. The highest level of B. bassiana colonization was observed in the roots at 10 days post-inoculation using the soil-wetting and leaf-spraying methods (Table 1).
Soil-wetting method significantly enhanced common bean growth
Inoculation of B. bassiana by soil-wetting and leaf-spraying resulted in enhanced plant growth, which was not observed with the seed-soaking method. Common bean growth parameters differed significantly based on the inoculation method at 10 days post-inoculation (Table 2).
In this work, three different inoculation methods and two different inoculation times were used. The parameters of plant growth that were measured included plant height, leaf number, and root length. At 10 days post-inoculation with the seed-soaking method, plant height was 20.00 cm (control height was 17.75 cm), the number of leaves was 6.50 sheet (control number was 6.50 sheet), and root length was 9.50 cm (control length was 8.75 cm). At 10 days post-inoculation with the leaf-spraying method, plant height was 43.50 cm (control height was 32.25 cm), number of leaves was 16.75 sheet (control number was 11.75 sheet), and root length was 30.00 cm (control length was 21.75 cm). At 10 days post-inoculation with the soil-wetting method, plant height was 49.25 cm (control height was 25.25 cm), the number of leaves was 19.25 sheet (control leaf number was 9.00 sheet), and root length was 32.25 cm (control root length was 24 cm) (Table 2).
At 20 days post-inoculation with the seed-soaking method, plant height was 51.00 cm (control height was 41.75 cm), the number of leaves was 20.75 sheet (control number was 15.75 sheet), and root length was 31.00 cm (control length was 23.25 cm). At 20 days post-inoculation with the leaf-spraying method, plant height was 67.75 cm (control height was 54.50 cm), number of leaves was 29.00 sheet (control number was 21.75 sheet), and root length was 38.25 cm (control length was 33.25 cm). At 20 days post-inoculation with the soil-wetting method, plant height was 68.50 cm (control height was 60 cm), the number of leaves was 29.75 sheet (control leaf number was 25.25 sheet), and root length was 40.5 cm (control root length was 36.00 cm).
Based on the results of these experiments, a post-inoculation time of 10 days was the most effective application time. Plant growth enhancement was observed with soil wetting and leaf spraying but not with seed-soaking.
Discussion
Identification of B. bassiana
Macroscopic and microscopic identification of B. bassiana in this work correlated with the following observations made by Barnett and Hunter [3]: B. bassiana is known as a white muscardine because its mycelium and conidium (conidia) are white, its single oval-shaped conidia are oval-like eggs, and its conidiophore grows in a zigzag pattern. Vega et al. [23] stated that B. bassiana was found in the seeds, leaves, and shoots of coffee plants. B. bassiana not only infects insects but can also be a symbiont of plants. Thus, when B. bassiana conidia are inoculated into plants, the conidia may become an endophyte of the common bean plant. Application of B. bassiana resulted in endophytic colonization of roots, stems, and leaves of tomato and cotton plants, which protected against the plant pathogens Rhizoctonia solani and Pythium myriotylum. The degree of disease control depends upon the population density of B. bassiana conidia [15].
Colonization by B. bassiana
This study examined three methods of inoculating the entomopathogenic fungus B. bassiana. The method of inoculation can impact the endophytic characteristics of B. bassiana in plants. Factors that influence the development of entomopathogenic fungi into endophytes are entomopathogenicity, fungus inoculation method, environmental compatibility, fungus life cycle, and plant reaction to the fungus [18]. The production of metabolites by fungi can help exploit these endophytic entomopathogenic properties to support plant resistance to pest and disease attacks. According to Qayyum et al. [18], B. bassiana can enter and form colonies on plant tissue via inoculation techniques. Many factors can influence the specific outcome of experiments that aim to establish a fungal entomopathogen as an endophyte. Biological factors of interest that can be addressed experimentally include the crop species or cultivar and the fungal entomopathogen species, strain, or isolate. Other factors to consider include the concentration of the inoculum, the age of the plant during inoculations, and the growth conditions of the plant [16].
The soil-wetting and leaf-spraying methods used in this study generated positive but the seed-soaking method did not. The soil-wetting-facilitated B. bassiana conidia attach to the root surface, then penetrate to grow and develop, then spread to the stems and roots. With the leaf-spraying method, B. bassiana attaches to the top and bottom leaf surfaces and grows and develops, then spreads to stems and roots. It is not yet clear why B. bassiana colonization is more effective using leaf-spraying in leaves and stems, but this may reflect different physiological conditions and microbial states in different parts of the plant. The tissue specificity of endophytic fungus may also play a role in the ability of different parts of plants to cope with and adapt to particular conditions [11, 17]. Based on previous research, for seed-treatment to increase growth of maize, high nutrient conditions are mandatory. If nutrients are not high enough, then the fungus tended to reduce plant growth [14].
Colonization levels of B. bassiana in cassava roots were higher when plants were sampled at 7–9 days post-inoculation (84%) as compared to 47–49 days post-inoculation (40%) [7]. All colonizing fungi detected by fungal cell wall (CW) staining are metabolically active in young plants, but this may not be the case in older plants (Smith et al. 1990; Abdel-Fattah 2001) in [9]. According to Yoo and Ting [25], the success of endophytic fungal inoculation, including colonization and growth, depends on the host plant.
According to Parsa et al. [16], a higher degree of colonization was observed for soil-wetting as compared to leaf-spraying. In coffee, foliar sprays favor leaf colonization whereas soil drenches favor root colonization [16]. According to Behie et al. [4], of a total of 514 Beauveria isolates at Ontario field sites, 74.3% were from roots, 11.9% were from the hypocotyl, and 13.8% were from the stem and leaves. The conidia of the fungus may stick to the root surface, then enter through the roots to the xylem vessels to spread to the stems and leaves [6]. The spread of B. bassiana in plants occurs through the vascular tissues of the xylem [10]. The ability of Beauveria to colonize above-ground plant tissues could allow for subsequent infection of above-ground herbivorous insects [4]. Beauveria is also capable of infecting insects found beneath the soil surface; however, host plants upon which the insects feed could potentially influence fungal pathogenicity (Santiago-Alvarez et al. 2006). According to Tefera and Vidal (2009), spraying with conidial suspensions of B. bassiana was the best method for introducing the fungus into sorghum leaves. When a B. bassiana conidia solution was sprayed onto maize, the fungus colonized the leaves and translocated to other tissues (Wagner and Lewis 2000 in Mantzoukas et al. 2015). Once hyphae on the leaf surface penetrate the cuticle, they follow the leaf apoplast and move through interconnected vascular tissues to colonize the entire plant (Mantzoukas et al. 2015).
Soil-wetting method significantly enhanced common bean growth
Our results demonstrated that inoculation of entomopathogenic B. bassiana improved growth of common bean plants. Inoculation of B. bassiana had a positive effect on plant growth parameters, which included plant height, number of leaves, and root length. Saikkonem et al. [19] stated that B. bassiana helps to transfer nutrients from the soil into the plant that helps to stimulate plant growth. Several studies have shown that inoculation of entomopathogenic B. bassiana had a positive effect on growth of cotton plants [15]. According to Akutse et al. [2], the Beauveria endophyte able to colonize the roots, stems, and leaves of P. vulgaris plants by soil-wetting treatment. Soil-wetting inoculation of conidial suspensions close to cassava stem cuttings resulted in endophytic colonization of cassava roots by B. bassiana and Metarhizium anisopliae, although neither was found in the leaves or stems of the treated cassava plants [7].
Conclusions
Inoculation of B. bassiana into Phaseolus vulgaris L. via seed-soaking, leaf-spraying, and soil-wetting demonstrated the potential of this fungus to function as a growth-promoting endophytic agent. Use of soil-wetting to inoculate B. bassiana conidia maximally increased the growth of Phaseolus vulgaris L. at 10 days post-inoculation. Compatibility of B. bassiana with plant parts (roots, stems, leaves) was demonstrated by macroscopic and microscopic identification.
Abbreviations
- BHT:
-
Butylated hydroxytoluene
- NaOCl:
-
Sodium hypochlorite
- PDA:
-
Potato dextrose agar
- ANOVA:
-
Analysis of variance
- CW:
-
Cell wall
References
Abdel-Fattah GM. Measurement of the viability of arbuscular-mycorrhizal fungi using threedifferent stains; relation to growth and metabolic activities of soybean plants. Microbiol. Res. 2001;156:359–67.
Akutse KS, Maniania NK, Fiaboe KKM, Berg JVD, Ekesi S. Endophytic colonization of Vicia faba and Phaseolus vulgaris (Fabaceae) by fungal pathogens and their effects on the life-history parameters of Liriomyza huidobrensis (Diptera: Agromyzidae). Fungal Ecol. 2013;6:293–301. https://doi.org/10.1016/j.funeco.2013.01.003.
Barnett HL, Hunter BB. Illustrated Marga of imperfect fungi. 4th ed. USA: Prentice-Hall, Inc; 1998. p. 90–5.
Behie SW, Jones SJ, Bidochka MJ. Plant tissue localization of the endophytic insect pathogenic fungi Metarhizium and Beauveria. Fungal Ecol. 2015;13:112–9. https://doi.org/10.1016/j.funeco.2014.08.001.
Beninger & Hosfield. Antioxidant activity of extracts, condensed tannin fractions, and pure flavonoids from Phaseolus vulgaris L. seed coat color genotypes. J Agric Food Chem. 2003;51:7879–83. https://doi.org/10.1021/jf0304324.
Fatahuddin, Amin N, Daud ID, Chandra Y. Uji kemampuan Beauveria bassiana Vuillemin (Hyphomycetes: Moniliales) sebagai endofit pada tanaman kubis dan penyaruh terhadap larva Plutella Xylostella L. (Lepidoptera: Yponomeutidae). FITOMRDIKA Jurnal Fitomedika. 2003;5(1):16–9.
Greenfield M, Gomez-Jimenez MI, Ortiz V, Vega FE, Kramer M, Paras S. Beauveria bassiana and Metarhizium anisopliae endophytically colonize cassava roots following soil drench inoculation. Biol Control. 2016;95:40–8.
Jaber LR, Araj S-E. Interactions among endophytic fungal entomopathogens (Ascomycota: Hypocreales), the green peach aphid Myzus persicae Sulzer (Homoptera: Aphididae), and the aphid endoparasitoid Aphidius colemani Viereck (Hymenoptera: Braconidae). Biol Control. 2018;116(2018):53–61.
Kobae Y, Ohtomo R, Oka N, Morimoto S. A simple model system for identifying arbuscular mycorrhizal fungal taxa that actively colonize rice (Oryza sativa L.) roots grown in field soil. Soil Sci Plant Nutr. 2017;63:29–36.
Landa BB, Lopez DC, Jimenez FD, Montes BM, Munoz LFJ, Ortiz UA, Quesada ME. In plant a detection and monitorization of endophytic colonization by a Beauveria bassiana strain using a new-developed nested and quantitative PCR-based assay and confocal laser scanning microscopy. J Invert Pathol. 2013;114:128–38. https://doi.org/10.1016/j.jip.2013.06.007.
Liang-Dong G, Guo-Rui H, Yu W. Seasonal and tissue age influences on endophytic fungi of Pinus tabulaeformis (Pinaceae) in the Dongling Mountains, Beijing. J Integr Biol. 2008;50:997–1003.
Lopez DC, Sword GA. The endophytic fungal entomopathogens Beauveria bassiana and Purpureocillium lilacinum enhance the growth of cultivated cotton (Gossypium hirsutum) and negatively affect survival of the cotton bollworm (Helicoverpa zea). J Biol Control. 2015;89:53–60. https://doi.org/10.1016/j.biocontrol.2015.03.010.
Mantzoukas S, Chondrogiannis C, dan Grammatikopoulos G. Effects of three endophytic entomopathogens on sweet sorghum and on the larvae of the stalk borer sesamia nonagrioides. J Entomol Soc Entomol Exp Appl 2015;154:78–87.
Meyling NV, Tall S. Probiotics for Plants? Growth promotion by the entomopathogenic fungus Beauveria bassiana depends on nutrient availability. Microb Ecol. 2018;76:1002–8.
Ownley BH, Griffin MR, Klingeman WE, Gwinn KD, Moulton JK, Pereira RM. Beauveria bassiana: endophytic colonization and plant disease control. J Invert Pathol. 2008;98:267–70. https://doi.org/10.1016/j.jip.2008.01.010.
Parsa S, Ortiz V, Vega FE. Establishing fungal entomopathogens as endophytes: towards endophytic biological control. JOVE J Vis Exp. 2013;74:1–5. https://doi.org/10.3791/50360.
Petrini O, Fisher PJ. Fungal endophytes in Salicornia perennis. Trans Br Mycol Soc. 1987;87:647–51.
Qayyum MA, Wakil W, Arif MJ, Sahi ST, Dunlap CA. Infection of Helicoverpa armigera by endophytic Beauveria bassiana colonizing tomato plants. J Biol Control. 2015;90:200–7. https://doi.org/10.1016/j.biocontrol.2015.04.005.
Saikkonem K, Mikola J, Helander M. Endophytic phyllosphere fungi and nutrient cyling in terrestrial ecosystems. J Curr Sci. 2015;109(1):121–5.
Santiago-Alvarez C, Maranhao EA, Maranhao E, Quesada-Moraga E. Host plant influence pathogenicity of Beauveria bassiana to Bemisia tabaci and its sporulation on cadavers. Biocontrol. 2006;51:519–32.
Sepulveda RB, Carrillo AA. The erosion threshold for a sustainable agriculture in cultures of bean (Phaseolus vulgaris L.) under conventional tillage and no-tillage in Northern Nicaragua. Soil Use Manag. 2016;32:368–80.
Tefera T, Vidal S. Effect of inoculation method and plant growth medium on endophytic colonizationof sorghum by the entomopathogenic fungus Beauveria bassiana. Biocontrol. 2009;54:663–9.
Vega FE, Posada F, Aime MC, Peterson SW, Rehner SA. Fungal endophyters in green coffee seeds. Mycosystema. 2008;27(1):75–84.
Wagner BL, dan Lewis LC. Colonization of Corn, Zea mays, by the Entomopathogenic Fungus Beauveria bassiana. J Appl Environ Microbiol. 2000;66:3468–73.
Yoo HS, Ting ASY. In vitro endophyte-host plant interaction study to hypothetically describe endophyte survival and antifungal activities in planta. Acta Biol Szegediensis. 2017;61(1):1–11.
Authors’ contributions
AA designed study and write this manuscript; TW, RNSH, and AALE conducted experiments, HT and MA analyzed the data and drafted the manuscript. All authors read and approved the final manuscript.
Acknowledgements
We thank the Post Graduate Program and Department of Pest Management, Faculty of Techno Agriculture, Brawijaya University for providing the facility to conduct this study.
Competing interests
The authors declare that they have no competing interests.
Availability of data and materials
Data included in this article.
Consent for publication
The data are original, no duplication and plagiarism, also have not publish in elsewhere.
Ethics approval and consent to participate
Not applicable.
Funding
Grant-in-Aid for Scientific Research (No. 13343) from the Japan Society for the Promotion of Sciences.
Publisher’s Note
Springer Nature remains neutral with regard to jurisdictional claims in published maps and institutional affiliations.
Author information
Authors and Affiliations
Corresponding author
Rights and permissions
Open Access This article is distributed under the terms of the Creative Commons Attribution 4.0 International License (http://creativecommons.org/licenses/by/4.0/), which permits unrestricted use, distribution, and reproduction in any medium, provided you give appropriate credit to the original author(s) and the source, provide a link to the Creative Commons license, and indicate if changes were made. The Creative Commons Public Domain Dedication waiver (http://creativecommons.org/publicdomain/zero/1.0/) applies to the data made available in this article, unless otherwise stated.
About this article
Cite this article
Afandhi, A., Widjayanti, T., Emi, A.A.L. et al. Endophytic fungi Beauveria bassiana Balsamo accelerates growth of common bean (Phaeseolus vulgaris L.). Chem. Biol. Technol. Agric. 6, 11 (2019). https://doi.org/10.1186/s40538-019-0148-1
Received:
Accepted:
Published:
DOI: https://doi.org/10.1186/s40538-019-0148-1